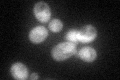
YHR200W
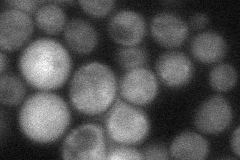
YHR200W
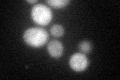
YHR200W
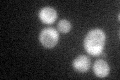
YHR200W
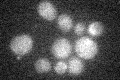
YHR200W

View description
Non-ATPase base subunit of the 19S regulatory particle (RP) of the 26S proteasome; N-terminus plays a role in maintaining the structural integrity of the RP; binds selectively to polyubiquitin chains; homolog of the mammalian S5a protein
Localization:
Intensity:
Fold change:
Significance:
-
C’ GFP library in SD
cytosol48.5 -
N' NOP1pr-GFP in SD

cytosol56.5069 -
N' TEF2pr-mCherry in SD

nucleus80.8881 -
N' NATIVEpr-GFP in SD
cytosol36.9743 -
N' TEF2pr-VC and Cyto-VN in SD

below threshold21.3441 -
C’ GFP library in SD+DTT
cytosol42.770.88No -
C’ GFP library in SD+H2O2
cytosol48.621No -
C’ GFP library in Starvation Media
cytosol20.710.42No -
C’ GFP library on the background of Pup2-DaMP

cytosol -
C’ GFP library on the background of CCT mutant

cytosol45.49370.937962No
